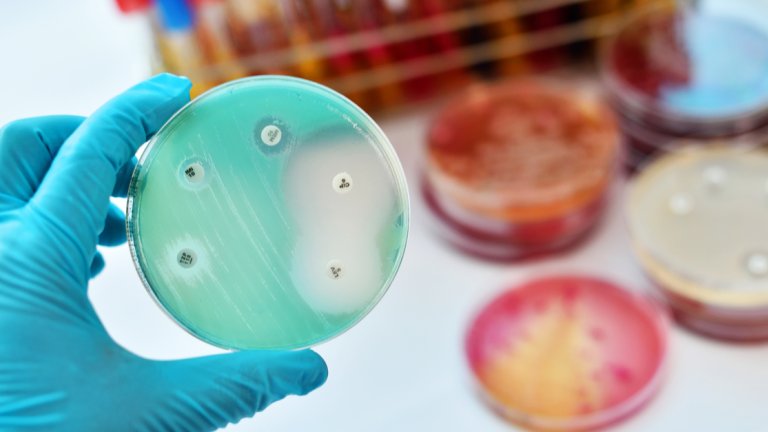

In een eind vorige maand verschenen artikel in Clinical and Microbiological Infection beschrijven dr. Elske Sieswerda en prof. Joost Wiersinga met hun team een wetenschappelijke richtlijn voor het gebruik van antibiotica bij covid-19-patiënten overal in de wereld. Sieswerda: “We wilden duidelijkheid krijgen, omdat deze patiënten wereldwijd vrijwel standaard antibiotica kregen bij opname. Dit gebeurde omdat de patiënten erg ziek zijn, met hoge koorts en ontstekingen, en flinke afwijkingen hadden op beeldvorming van de longen.”
Luchtweginfectie
Dat veel artsen naar antibiotica grijpen is begrijpelijk omdat de ernstig zieke coronapatiënt vaak een luchtweginfectie heeft. Voor een longontsteking door een bacterie wordt antibiotica gegeven. Maar corona is een virus, waarvoor antibiotica niet werkt. Maar het was zeker in het begin van de pandemie niet duidelijk of er ook een bacterie meespeelde in de longontsteking. Dit komt doordat het lastig is de effecten van een ernstige longontsteking door een virus te onderscheiden van een longontsteking door een bacterie.
Sieswerda: “In Amsterdam UMC en in de literatuur merkten we dat tijdens het begin van de pandemie vrijwel alle opgenomen coronapatiënten antibiotica kregen, maar dat er vrijwel geen bacteriële verwekkers werden aangetoond. Antibioticagebruik leidt tot resistentievorming bij bacteriën en gezien de pandemie leek er een risico op veel onnodig antibioticagebruik en dus op toename van het resistentieprobleem.”
Terughoudend
Uit alle bestaande studies naar antibiotica en covid-19-patiënten wisten de onderzoekers cijfers te destilleren. Slechts 3,5 procent van de patiënten had een bacteriële longontsteking bij opname en ruim 15 procent kreeg die infectie tijdens het verblijf in het ziekenhuis. Dat heet een secundaire infectie. Sieswerda adviseert op basis van deze getallen om -ondanks dat de getallen nog niet zeker zijn- terughoudend te zijn met antibiotica bij opname in het ziekenhuis voor covid-19.
Uiteraard moeten artsen beducht zijn op de mogelijkheid van een bacteriologische infectie. Sieswerda adviseert daarom om kweken van sputum en bloed van coronapatiënten te onderzoeken op de aanwezigheid van ziekmakende bacteriën. Als die er niet zijn dan is het advies om te stoppen met het geven van antibiotica. Patiënten die wel een bacteriële luchtweginfectie hebben naast covid-19 moeten een korte behandeling krijgen. Secundaire infecties lijken net als bij andere opgenomen patiënten op te treden en voor de behandeling hiervan verwijst Sieswerda naar bestaande richtlijnen.
Grotere studie
Sieswerda concludeert: “Een grotere studie over bacteriële infecties in COVID-19 is dringend noodzakelijk om onze conclusies te bevestigen en zo nog meer onnodig antibioticagebruik te voorkomen tijdens de huidige coronapandemie. Op initiatief van het Amsterdam UMC Antibiotic Stewardship team, dat tot doel heeft het voorschrijven van antibiotica te verbeteren, zijn we daarmee begonnen.”




